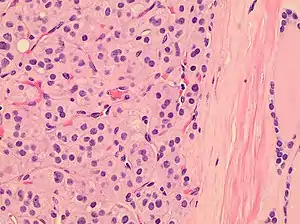

Hürthle cell neoplasm
Hürthle cell neoplasm is a rare tumor of the thyroid, typically seen in women between the ages of 70 and 80 years old. When benign, it is called a Hürthle cell adenoma, and when malignant it is called a Hürthle cell carcinoma. Hürthle cell adenoma is characterized by a mass of benign Hürthle cells (Askanazy cells).[1] Typically such a mass is removed because it is not easy to predict whether it will transform into the malignant counterpart of Hürthle cell carcinoma, which is a subtype of follicular thyroid cancer.[2][3]
| Hürthle cell neoplasm | |
|---|---|
| |
| Histopathology of a Hürthle cell adenoma | |
| Specialty | Oncology |

Histology
Hürthle cells are characterized as enlarged epithelial cells. These cells, when stained with hematoxylin-eosin show as pink. This is due to the abundant mitochondria and granular eosinophilic matter within the cells' cytoplasm. These cells are often found in the thyroid. The thyroid is a butterfly-shaped organ, responsible for producing various hormones for metabolism. These cells are often benign, but they can be malignant and metastasize. Hürthle cells are resistant to radiation, but can be treated using radioactive iodine treatment.[4]
Diagnosis
This mass can be detected and removed before transformation and metastasis. The tumor is often detected by imaging such as ultrasound. The location and size of the tumor may cause pressure and pain to the patient. But often the tumor goes undetected. After detection, the mass is tested using an invasive fine-needle aspiration biopsy.[5] Hürthle cell adenoma is the benign analogue of Hürthle cell carcinoma. This adenoma is extremely rare; when it occurs, it usually occurs in women. Often the adenoma is harmless but is removed after detection because its future course cannot be trusted.[2][3]
Cytopathology

Cytopathology cannot distinguish Hürthle cell adenoma from Hürthle cell carcinoma, which requires histopathologic sections to see transcapsular or vascular invasion. Hürthle cell hyperplasia (as seen in Hashimoto's thyroiditis) may show moderate variation in nuclear sizes and prominent nucleoli, but further findings favoring Hürthle cell neoplasm include a large number of Hürthle cells, and discohesiveness.[7]
Treatment
There are three main treatments for Hürthle cell adenomas. Once the adenoma is detected most often the nodules removed to prevent the cells from later metastisizing.[2][3] A total thyroidectomy is often performed, this results in a complete removal of the thyroid. Some patients may only have half of their thyroid removed, this is known as a thyroid lobectomy. Another treatment option includes pharmacological suppression of thyroid hormone. The thyroid gland is responsible for producing the thyroid hormones triiodothyronine (T3) and thyroxine (T4). Patients with suppressed thyroid function often require oral thyroid replacement (e.g. levothyroxine) in order to maintain normal thyroid hormone levels. The final treatment option is RAI ablation (radioactive iodine ablation). This treatment option is used to destroy infected thyroid cells after total thyroidectomy. This treatment does not change prognosis of disease, but will diminish the recurrence rate. Also, Hürthle cells do not respond well to RAI. However, often doctors suggest this treatment to patients with Hürthle cell adenoma and Hürthle cell carcinoma because some Hürthle cells will respond and it will kill remaining tissue.[1]
History
The first Hürthle cell adenoma was discovered by Dr James Ewing in 1928. Hürthle cells were discovered in the 1890s and are named after Karl Hürthle and Max Askanazy.
References
- "Thyroid Cancer: About Thyroid Cancer | Memorial Sloan Kettering Cancer Center". www.mskcc.org. Retrieved 2015-11-23.
- Ristevska, N; Stojanoski, S; Gjorceva, DP (2015), "Appearance of Hürthle cell carcinoma soon after surgical extirpation of Hürthle cell adenoma and follicular adenoma of the thyroid gland", Radiol Oncol, 49 (1): 26–31, doi:10.2478/raon-2014-0047, PMC 4362603, PMID 25810698.
- Wasvary, H; et al. (1998), "Unilateral lobectomy for Hürthle cell adenoma", Am Surg, 64 (8): 729–732, PMID 9697901.
- "Hurthle Cell Adenoma". www.knowcancer.com. Retrieved 2015-11-23.
- "Follicular and Hurthle Cell Thyroid Cancer | Columbia University Department of Surgery". columbiasurgery.org. Retrieved 2015-11-23.
- Image by Mikael Häggström, MD. References for findings:
- Ayana Suzuki, C.T., Andrey Bychkov, M.D., Ph.D. "Hürthle cell neoplasm". Pathology Outlines.{{cite web}}: CS1 maint: multiple names: authors list (link) Last author update: 7 May 2020. Last staff update: 12 May 2022
- Shawky M, Sakr M (2016). "Hurthle Cell Lesion: Controversies, Challenges, and Debates". Indian J Surg. 78 (1): 41–8. doi:10.1007/s12262-015-1381-x. PMC 4848220. PMID 27186039. - - Ayana Suzuki, C.T., Andrey Bychkov, M.D., Ph.D. "Hürthle cell neoplasm". Pathology Outlines.
{{cite web}}: CS1 maint: multiple names: authors list (link) Last author update: 7 May 2020. Last staff update: 12 May 2022
- Shawky M, Sakr M (2016). "Hurthle Cell Lesion: Controversies, Challenges, and Debates". Indian J Surg. 78 (1): 41–8. doi:10.1007/s12262-015-1381-x. PMC 4848220. PMID 27186039.